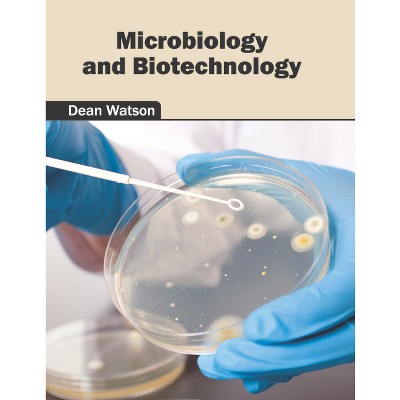

Progress and Technological Challenges in Microbial Biotechnology - by Igor Melnikov (Hardcover)

$144.99 when purchased online
Target Online store #3991
About this item
Highlights
- The recent advances in science and technology have paved way for genetic modification.
- Author(s): Igor Melnikov
- 218 Pages
- Science, Life Sciences
Description
About the Book
The recent advances in science and technology have paved way for genetic modification. Microbial biotechnology is concerned with such manipulation for producing useful products for various industries such as pharmaceuticals, food industry, etc. This book focuses on the applications of microbial biotechnology and its industrial uses. It also comprises of topics related to protein engineering, functional genomics, biomaterials, etc. It will serve as an extensive source of reference for students and professionals alike. This text covers topics such as microbes in agrobiotechnology, impact of global warming on microbes, microbes in environmental biotechnology, etc. in a coherent manner. Researchers and students in the field of biotechnology will be greatly assisted by this book.Book Synopsis
The recent advances in science and technology have paved way for genetic modification. Microbial biotechnology is concerned with such manipulation for producing useful products for various industries such as pharmaceuticals, food industry, etc. This book focuses on the applications of microbial biotechnology and its industrial uses. It also comprises of topics related to protein engineering, functional genomics, biomaterials, etc. It will serve as an extensive source of reference for students and professionals alike. This text covers topics such as microbes in agrobiotechnology, impact of global warming on microbes, microbes in environmental biotechnology, etc. in a coherent manner. Researchers and students in the field of biotechnology will be greatly assisted by this book.Dimensions (Overall): 11.0 Inches (H) x 8.5 Inches (W) x .56 Inches (D)
Weight: 1.77 Pounds
Suggested Age: 22 Years and Up
Number of Pages: 218
Genre: Science
Sub-Genre: Life Sciences
Publisher: Syrawood Publishing House
Theme: Microbiology
Format: Hardcover
Author: Igor Melnikov
Language: English
Street Date: May 31, 2016
TCIN: 1005848109
UPC: 9781682861356
Item Number (DPCI): 247-02-6810
Origin: Made in the USA or Imported
If the item details aren’t accurate or complete, we want to know about it.
Shipping details
Estimated ship dimensions: 0.56 inches length x 8.5 inches width x 11 inches height
Estimated ship weight: 1.77 pounds
We regret that this item cannot be shipped to PO Boxes.
This item cannot be shipped to the following locations: American Samoa (see also separate entry under AS), Guam (see also separate entry under GU), Northern Mariana Islands, Puerto Rico (see also separate entry under PR), United States Minor Outlying Islands, Virgin Islands, U.S., APO/FPO
Return details
This item can be returned to any Target store or Target.com.
This item must be returned within 90 days of the date it was purchased in store, shipped, delivered by a Shipt shopper, or made ready for pickup.
See the return policy for complete information.
Trending Poetry

$22.80
was $26.60 New lower price
5 out of 5 stars with 4 ratings